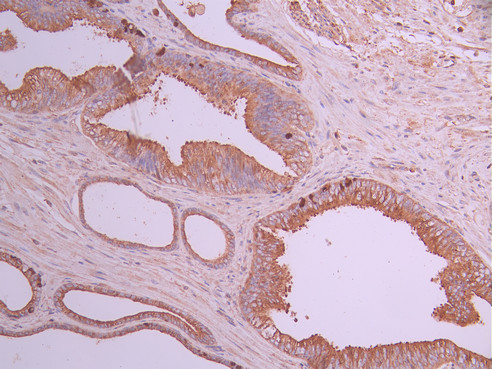

CAPN1 Recombinant Monoclonal Antibody
-
中文名稱:CAPN1 Recombinant Monoclonal Antibody
-
貨號:CSB-RA163699A0HU
-
規格:¥1320
-
圖片:
-
IHC image of CSB-RA163699A0HU diluted at 1:100 and staining in paraffin-embedded human prostate cancer performed on a Leica BondTM system. After dewaxing and hydration, antigen retrieval was mediated by high pressure in a citrate buffer (pH 6.0). Section was blocked with 10% normal goat serum 30min at RT. Then primary antibody (1% BSA) was incubated at 4°C overnight. The primary is detected by a Goat anti-rabbit polymer IgG labeled by HRP and visualized using 0.05% DAB.
-
Immunofluorescence staining of MCF-7 cell with CSB-RA163699A0HU at 1:50, counter-stained with DAPI. The cells were fixed in 4% formaldehyde and blocked in 10% normal Goat Serum. The cells were then incubated with the antibody overnight at 4°C. The secondary antibody was Alexa Fluor 488-congugated AffiniPure Goat Anti-Rabbit IgG(H+L).
-
Overlay Peak curve showing BxPC-3 cells stained with CSB-RA163699A0HU (red line) at 1:100. The cells were fixed in 4% formaldehyde and permeated by 0.2% TritonX-100 for 10min. Then 10% normal goat serum to block non-specific protein-protein interactions followed by the antibody (1ug/1*106cells) for 45min at 4℃. The secondary antibody used was FITC-conjugated goat anti-rabbit IgG (H+L) at 1/200 dilution for 35min at 4℃.Control antibody (green line) was Rabbit IgG (1ug/1*106cells) used under the same conditions. Acquisition of >10,000 events was performed.
-
-
其他:
產品詳情
-
Uniprot No.:
-
基因名:
-
別名:Calpain-1 catalytic subunit (EC 3.4.22.52) (Calcium-activated neutral proteinase 1) (CANP 1) (Calpain mu-type) (Calpain-1 large subunit) (Cell proliferation-inducing gene 30 protein) (Micromolar-calpain) (muCANP), CAPN1, CANPL1
-
反應種屬:Human
-
免疫原:A synthesized peptide from human CAPN1 protein
-
免疫原種屬:Homo sapiens (Human)
-
標記方式:Non-conjugated
-
克隆類型:Monoclonal
-
抗體亞型:Rabbit IgG
-
純化方式:Affinity-chromatography
-
克隆號:6D9
-
濃度:It differs from different batches. Please contact us to confirm it.
-
保存緩沖液:Preservative: 0.03% Proclin 300
Constituents: 50% Glycerol, 0.01M PBS, PH 7.4 -
產品提供形式:Liquid
-
應用范圍:ELISA, IHC, IF, FC
-
推薦稀釋比:
Application Recommended Dilution IHC 1:50-1:200 IF 1:50-1:200 FC 1:50-1:200 -
Protocols:
-
儲存條件:Upon receipt, store at -20°C or -80°C. Avoid repeated freeze.
-
貨期:Basically, we can dispatch the products out in 1-3 working days after receiving your orders. Delivery time maybe differs from different purchasing way or location, please kindly consult your local distributors for specific delivery time.
-
用途:For Research Use Only. Not for use in diagnostic or therapeutic procedures.
相關產品
靶點詳情
-
功能:Calcium-regulated non-lysosomal thiol-protease which catalyzes limited proteolysis of substrates involved in cytoskeletal remodeling and signal transduction. Proteolytically cleaves CTBP1 at 'Asn-375', 'Gly-387' and 'His-409'.
-
基因功能參考文獻:
- Unexpected role of the L-domain of calpastatin during the autoproteolytic activation of human erythrocyte calpain. PMID: 29572388
- Studies indicate that reactive oxygen and nitrogen species (RONS) and calpain play important roles in the development of airway and pulmonary vascular remodeling in COPD. PMID: 29047085
- Calpain-1 was significantly expressed in Triple-negative breast cancer tissues varying from low to high with a significant correlation to lymph node status but not with the other clinicopathological variables, suggesting its role as a prognostic factor PMID: 28536704
- These findings suggest that calpain and AR-V7 may serve as important biomarkers in the treatment of castration-resistant prostate cancer , and targeting calpain and AR-V7 may provide a new approach in overcoming docetaxel-resistance. PMID: 28498452
- Rare homozygous and compound-heterozygous nonsense, missense, frameshift, and splice-site mutations in CAPN1 were identified in all hereditary spastic paraplegia affected individuals, and sequencing in additional family members confirmed the segregation of these mutations with the disease. PMID: 27153400
- the cleavage of myoferlin, yielding a membrane-associated dual C2 domain 'mini-myoferlin', is reported. PMID: 28192161
- mutations in CAPN1 are an additional cause of ataxia in mammals, including humans. PMID: 27320912
- Calpain-1 expression is associated with poor relapse-free survival in breast cancer patients treated with trastuzumab. PMID: 26496999
- Regulation of platelet-activating factor-mediated PTP1B activation by a Janus kinase 2/ calpain pathway has been reported. PMID: 28686728
- HRNR deimination improves its cross-linking by TGases and its proteolytic processing by calpain-1. PMID: 27742573
- calpains and calpastatin in patients with idiopathic pulmonary arterial hypertension (PAH) and mice with hypoxic or spontaneous (SM22-5HTT(+) strain) PH, were investigated. PMID: 26974350
- calpain and protein kinase Calpha abnormal release promotes a constitutive release of matrix metalloproteinase 9 in peripheral blood mononuclear cells from cystic fibrosis patients PMID: 27349634
- Endoplasmic reticulum stress may be associated with apoptosis of LECs, resulting in cataract formation in diabetic patients. PMID: 27130368
- our findings suggest that the gene/protein expression of both CAPN1 and CAPN2, as well as the ERK1 and ERK2 genes and related proteins, could be molecular factors associated with more invasive tumor behavior in squamous cell laryngeal cancer. PMID: 27456359
- This study demonstrated that Upregulation of calpain activity precedes tau phosphorylation and loss of synaptic proteins in Alzheimer's disease brain. PMID: 27036949
- the calpain-dependent cleavage of Nav1.6 channels expressed in human embryonic kidney (HEK) 293 cells caused the upregulation of I(NaP) PMID: 26974309
- Increased mu-Calpain Activity in Blasts of Common B-Precursor Childhood Acute Lymphoblastic Leukemia Correlates with Their Lower Susceptibility to Apoptosis. PMID: 26317226
- Data indicate that calpain is responsible for processing translation termination factor eRF3 into its IAP-binding isoform p-eRF3. PMID: 26172506
- NOS stimulation via PI3K, calpain proteases, and SIRT1-dependent deacetylation downstream from VEGFR2 activation contributes to these vasodilator responses. PMID: 26284543
- Junctophilin-2 is cleaved by calpain at multiple sites, resulting in dysfunctional junctophilin-2 truncations. PMID: 26063807
- The results of this study indicated that reductions in kallikrein-6 and calpain-1 may contribute to the accumulation of alpha-synuclein in DLB. PMID: 25476568
- findings suggest that truncation/activation of Dyrk1A by Ca(2+)/calpain I might contribute to Tau pathology via promotion of exon 10 exclusion and hyperphosphorylation of Tau in AD brain PMID: 25918155
- 5-LOX inhibition reduced apoptotic death, restored the initial IL-2/INF-gamma ratio, and more importantly reverted micro-calpain activation induced by simulated microgravity. PMID: 25309925
- the p12/Pol delta is a target as a nuclear substrate of mu-calpain in a calcium-triggered apoptosis and appears to be a potential marker in the study of the chemotherapy of cancer therapies. PMID: 24691096
- Data show the X-ray structures of calpain with (Z)-3-(4-chlorophenyl)-2-mercaptoacrylic acid and (Z)-3-(5-bromoindol-3-yl)-2-mercaptoacrylic acid. PMID: 25086406
- CAPN1 anchors to two NCX1 regions and cleaves at methionine-369, leading to NCX1 inactivation in heart failure. PMID: 25336645
- Besides, calpain-1, a calcium-dependent cysteine protease, was involved inherpes simplex virus type 1 intracellular trafficking. PMID: 24670325
- Ayloid beta mediates calpain cleavage of NCX3 in Alzheimer's disease brain. PMID: 23919677
- Increased trophoblast apoptosis and altered expression levels of syncytin-1, calpain 1, and AIF is observed in preeclamptic placentas. PMID: 24413738
- The PC1 function on JAK2 and ERK signaling pathways might be regulated by calpains in response to the changes in intracellular calcium concentration. PMID: 24416790
- Small interfering RNA (siRNA)-mediated silencing of micro-calpain expression significantly suppressed the adhesive, migrative and invasive potentials of human hepatoma cells. PMID: 23733271
- HER2 inhibited calpain-1 activity through upregulating calpastatin, an endogenous calpain inhibitor. PMID: 23707532
- Calpain activation via Ca(2) flux plays an essential role in eliciting an AIF-mediated, caspase-independent apoptotic pathway in EV71-infected cells. PMID: 23515028
- a truncated fragment of Src protein kinase generated by calpain-mediated cleavage is a mediator of neuronal death in excitotoxicity PMID: 23400779
- Extracellular signal-regulated kinase and glycogen synthase kinase 3beta regulate gephyrin postsynaptic aggregation and GABAergic synaptic function in a calpain-dependent mechanism PMID: 23408424
- Proteolysis of calcineurin A by endogenous calpain I leads to the formation of constitutively active calcineurin in the human heart, which may contribute to the pathogenesis of myocardial disease PMID: 23289183
- Data indicate that calpain-1 plays a pivotal role in matrix metalloproteinase 2 (MMP2) activation and extracellular matrix remodeling, including fibrosis and vascular calcification. PMID: 23006733
- Report synthesis of emodin derivatives, emodin carbaldehyde, citreorosein, and their 10-deoxygenated derivatives and their inhibitory activities on mu-calpain. PMID: 22477191
- Results show that estrogen may contribute to both up-regulation and proteolysis of cyclin E through calpain in MCF-7 cells. PMID: 22449977
- APP secretion from the calpain overexpressing cells was robustly increased under both resting and stimulated conditions over wild-type cells. PMID: 22480599
- Overexpression of mu-calpain in the anterior temporal neocortex is associated with intractable epilepsy as well as the clinicopathological characteristics in these patients. PMID: 21315622
- Data show neutrophil calpain I (mu-calpain) was inactiveted by alpha1-antitrypsin. PMID: 21494752
- With higher grading of the ovarian carcinoma, staining intensity and immunoreactive score of calpain 1 decreased. PMID: 22335024
- Results show high levels of the 17-kDa tau fragment and enhanced calpain activity in the temporal cortex of AD patients and in brain samples obtained from patients with other tauopathies. PMID: 21442128
- The expression of mu-calpain-induced degradation products of extracellular matrix was correlated with the degree of disc degeneration in human intervertebral disc tissue PMID: 21839844
- siRNA knockdown of calpain prevented deltamethrin-induced DNA fragmentation. PMID: 21555338
- it is possible to protect cells from paclitaxel-induced degradation of NCS-1 by inhibiting calpain activity PMID: 21808066
- Data show that transfection of cells with GRP78 or calpain I and calpain II siRNA reduced MPTB-mediated cell apoptosis in chondrosarcoma JJ012 cells PMID: 21374734
- Findings show that p73alpha and its regulation by the Ca(2+)-mediated calpain pathway are involved in CDDP-induced apoptosis in OVCA cells and that dysregulation of Ca(2+)/calpain/p73 signaling may in part be the pathophysiology of CDDP resistance. PMID: 21516125
- Rad21 cleavage by calpain-1 promotes separation of chromosome arms, which coincides with a calcium-induced partial loss of cohesin at several chromosomal loci. PMID: 21876002
顯示更多
收起更多
-
相關疾病:Spastic paraplegia 76, autosomal recessive (SPG76)
-
亞細胞定位:Cytoplasm. Cell membrane.
-
蛋白家族:Peptidase C2 family
-
組織特異性:Ubiquitous.
-
數據庫鏈接:
Most popular with customers
-
-
YWHAB Recombinant Monoclonal Antibody
Applications: ELISA, WB, IHC, IF, FC
Species Reactivity: Human, Mouse, Rat
-
Phospho-YAP1 (S127) Recombinant Monoclonal Antibody
Applications: ELISA, WB, IHC
Species Reactivity: Human
-
-
-
-
-